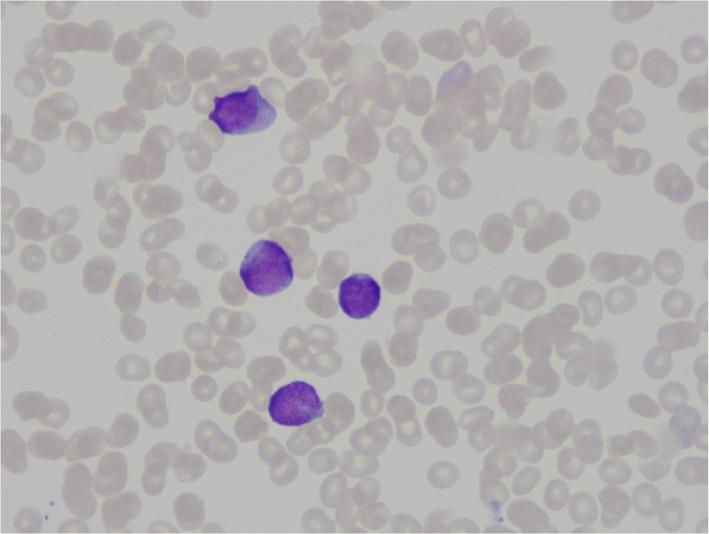
https://cdn.ncbi.nlm.nih.gov/pmc/blobs/a649/6413452/d6c8fc4c7dd0/13256_2018_1947_Fig2_HTML.jpg

由粘液罗氏菌引起的中性粒细胞减少患者的脑膜炎:一例报告
Meningitis in a patient with neutropenia due to Rothia mucilaginosa: a case report.
作者信息
Clauwaert Maxim, Druwé Patrick, Depuydt Pieter
机构信息
Intensive Care Unit, Universitair Ziekenhuis Gent, C. Heymanslaan 10, 9000, Ghent, Belgium.
出版信息
J Med Case Rep. 2019 Mar 12;13(1):84. doi: 10.1186/s13256-018-1947-x.
BACKGROUND
Rothia mucilaginosa is a Gram-positive bacterium occurring as a commensal in the oral cavity and upper respiratory tract. Although rarely pathogenic in an immunocompetent host, it can cause severe opportunistic infections in immunocompromised individuals.
CASE PRESENTATION
A 67-year-old white woman had a routine blood analysis before undergoing knee surgery. The results showed leukopenia for which bone marrow examination was performed, showing an underlying acute myeloid leukemia. During the neutropenic phase after a second induction with cytarabine/idarubicin, she developed fever, headaches, and photophobia. Cultures of cerebrospinal fluid were positive for Rothia mucilaginosa. Despite full therapy with antibiotics, neurosurgical interventions, and intensive care support, our patient died due to refractory intracranial hypertension and transtentorial herniation.
CONCLUSIONS
Meningitis due to Rothia mucilaginosa is a rare but potentially lethal infection in patients with neutropenia, and evidence-based guidelines for the treatment of this disease are lacking. We suggest an empirical therapy with amoxicillin/rifampicin until adjustments can be made based on an antibiogram. Intrathecal or intraventricular administration of antibiotics can be considered if neurosurgical access is already obtained because of disease-associated complications.
背景
黏液罗氏菌是一种革兰氏阳性菌,作为共生菌存在于口腔和上呼吸道。虽然在免疫功能正常的宿主中很少致病,但它可在免疫功能低下的个体中引起严重的机会性感染。
病例报告
一名67岁白人女性在接受膝关节手术前进行了常规血液分析。结果显示白细胞减少,为此进行了骨髓检查,结果显示患有潜在的急性髓系白血病。在第二次使用阿糖胞苷/伊达比星诱导治疗后的中性粒细胞减少期,她出现了发热、头痛和畏光症状。脑脊液培养黏液罗氏菌呈阳性。尽管接受了抗生素的全程治疗、神经外科干预和重症监护支持,但我们的患者因难治性颅内高压和小脑幕切迹疝死亡。
结论
黏液罗氏菌引起的脑膜炎在中性粒细胞减少患者中是一种罕见但可能致命的感染,且缺乏针对该疾病的循证治疗指南。我们建议经验性使用阿莫西林/利福平治疗,直到可根据药敏试验结果进行调整。如果因疾病相关并发症已进行神经外科手术,可考虑鞘内或脑室内给予抗生素。